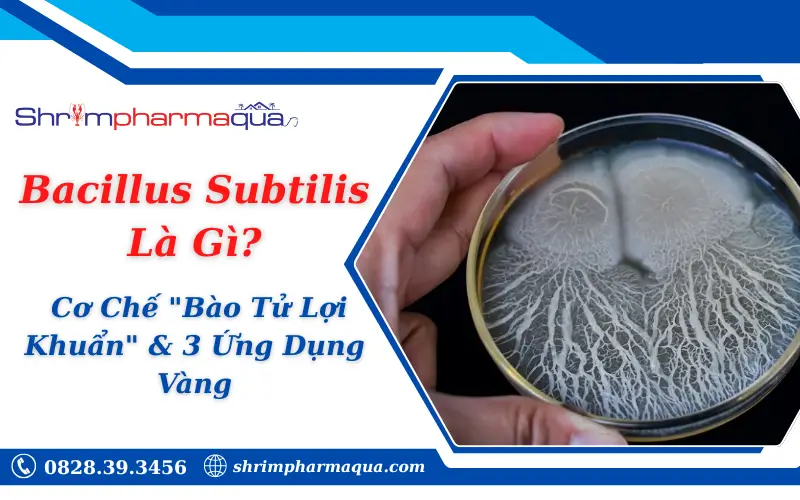
Bacillus Subtilis Là Gì? Cơ Chế "Bào Tử Lợi Khuẩn" & 3 Ứng Dụng Vàng

Bacillus subtilis (hay còn gọi là trực khuẩn cỏ khô) là một loại vi sinh vật thuộc nhóm Gram dương (Gram +), hiếu khí, nổi bật với khả năng tạo bào tử (endospore) cực kỳ bền vững.
Điểm khác biệt cốt lõi của B. subtilis so với các lợi khuẩn thường là khả năng tự bao bọc trong lớp vỏ bào tử cứng, giúp nó chịu được nhiệt độ cao (lên đến 80-100°C), sống sót qua axit dạ dày (pH 2-3) và kháng sinh liều thấp để đến ruột non an toàn và phát huy tác dụng.
1. Đặc Điểm Sinh Học & Cơ Chế Hoạt Động
Tóm tắt: Bacillus subtilis hoạt động dựa trên 3 cơ chế vàng: (1) Tạo bào tử kháng nhiệt/axit để bảo vệ sự sống, (2) Sản sinh hơn 70 loại kháng sinh và hệ enzyme thủy phân mạnh mẽ, (3) Cạnh tranh sinh học quyết liệt để loại bỏ vi khuẩn có hại.

Không giống như các loại men vi sinh thông thường dễ chết khi vận chuyển hoặc đi qua dạ dày, Bacillus subtilis hoạt động như một “nhà máy sinh học” với 3 cơ chế chính:
A. Tạo Bào Tử (Sporulation) – “Áo Giáp” Bảo Vệ
Khi gặp môi trường khắc nghiệt (thiếu thức ăn, nhiệt độ cao), vi khuẩn này chuyển sang trạng thái “ngủ đông” (bào tử).
- Khả năng chịu nhiệt: Sống tốt trong quá trình ép viên thức ăn chăn nuôi hoặc bảo quản nhiệt độ thường (lên tới 100°C trong thời gian ngắn).
- Khả năng chịu axit: Đi qua dịch vị dạ dày mà không bị tiêu diệt, đảm bảo số lượng sống sót >90% khi xuống ruột non.
B. Sản Sinh Enzyme Tiêu Hóa Mạnh
Bacillus subtilis có khả năng tổng hợp hơn 70 loại kháng sinh tự nhiên và nhiều enzyme thủy phân quan trọng giúp vật nuôi hấp thụ dinh dưỡng tối đa:
- Amylase: Thủy phân tinh bột.
- Protease: Phân giải protein (đạm).
- Lipase: Phân giải chất béo.
- Cellulase: Biến đổi chất xơ thành đường đơn.
C. Cạnh Tranh Sinh Học (Competitive Exclusion)
Vi khuẩn này tiêu thụ oxy nhanh chóng và chiếm chỗ bám trên niêm mạc ruột, khiến các vi khuẩn có hại không còn nơi trú ngụ và nguồn dinh dưỡng để phát triển.
2. Ứng Dụng Thực Tế Trong Nuôi Trồng Thủy Sản (Tôm/Cá)
Trong thủy sản, B. subtilis là “chìa khóa” để xử lý nước và đường ruột. Nó giúp phân hủy mùn bã đáy ao, cắt giảm khí độc NH3/NO2, và ức chế vi khuẩn Vibrio gây bệnh gan tụy.
Đây là lĩnh vực sử dụng B. subtilis nhiều nhất hiện nay, đóng vai trò chủ chốt trong các dòng men vi sinh công nghệ cao.

A. Xử Lý Đáy Ao & Môi Trường Nước
- Phân hủy mùn bã hữu cơ: B. subtilis tiết enzyme phân hủy thức ăn thừa, phân tôm và xác tảo chết tích tụ dưới đáy. Đây là giải pháp xử lý đáy ao nuôi hiệu quả, ngăn chặn sự hình thành lớp bùn đen và nhớt bạt.
- Giảm khí độc cấp tốc: Quá trình phân hủy mạnh mẽ giúp cắt giảm nguồn gốc sinh ra các khí độc nguy hiểm như Amoniac (NH3), Nitrit (NO2) và H2S.
- Giảm nhớt bạt: Một số chủng Bacillus đặc hiệu (kết hợp enzyme) có khả năng cắt đứt liên kết biofilm, giúp xử lý nước ao tôm bị nhớt nhanh chóng.
Sử dụng
Micro-R (vi sinh xử lý nước) hoặc
Astro Bio (vi sinh viên xử lý đáy) định kỳ để duy trì chất lượng nước. Đối với ao bạt bị nhớt nhiều, có thể kết hợp thêm
Neozyme.
B. Hỗ Trợ Đường Ruột & Phòng Bệnh
- Ức chế mầm bệnh: Cạnh tranh trực tiếp và tiết chất kháng khuẩn ức chế vi khuẩn Vibrio gây bệnh gan tụy, phân trắng. Điều này giúp hạn chế tình trạng tôm bị stress do áp lực dịch bệnh.
- Hỗ trợ tiêu hóa: Bổ sung B. subtilis vào thức ăn giúp tôm hấp thụ tốt hơn, giảm hệ số FCR (hệ số chuyển đổi thức ăn).
Các dòng men tiêu hóa như
Poli Bio hoặc
Astro Aqua thường chứa mật độ cao
Bacillus subtilis chuyên dùng cho đường ruột tôm.
3. Ứng Dụng Trong Y Tế & Sức Khỏe Con Người
B. subtilis giúp cân bằng hệ vi sinh sau liệu trình kháng sinh, kích thích sản sinh kháng thể IgA tăng miễn dịch và giảm nhanh các triệu chứng rối loạn tiêu hóa.

Trong y học, B. subtilis được xem là “vua” của các dòng men vi sinh dạng ống/nước nhờ tính bền vững:
- Cân bằng hệ vi sinh đường ruột: Đặc biệt hiệu quả sau khi dùng kháng sinh dài ngày (gây loạn khuẩn).
- Kích thích miễn dịch: Bào tử kích thích cơ thể sản sinh kháng thể IgA tại niêm mạc ruột.
- Hỗ trợ tiêu hóa: Giúp giảm các triệu chứng đầy hơi, khó tiêu, táo bón hoặc tiêu chảy cấp.
4. Mức Độ An Toàn & Lưu Ý Khi Sử Dụng
Đạt chứng nhận GRAS (An toàn tuyệt đối) từ FDA Hoa Kỳ. Lưu ý quan trọng nhất là cần sục khí mạnh khi sử dụng vì đây là vi khuẩn hiếu khí.
Theo Cục Quản lý Thực phẩm và Dược phẩm Hoa Kỳ (FDA), Bacillus subtilis được xếp vào nhóm GRAS (Generally Recognized As Safe) – Chứng nhận an toàn tuyệt đối.
Tuy nhiên, trong quá trình cách xử lý nước trong ao tôm hoặc dùng cho người, cần lưu ý:
- Chủng giống: Phải sử dụng đúng chủng (strain) đã được định danh.
- Sục khí (trong thủy sản): Khi ủ hoặc đánh vi sinh Bacillus xuống ao, cần chạy quạt nước mạnh vì vi khuẩn này là dòng hiếu khí (cần nhiều oxy) để hoạt động. Nếu thiếu oxy, hiệu quả xử lý khí độc ao tôm sẽ giảm sút đáng kể.
Bảng So Sánh Nhanh: B. Subtilis vs. Lactobacillus
| Đặc điểm | Bacillus subtilis | Lactobacillus (Sữa chua) |
|---|
| Dạng tồn tại | Bào tử & Tế bào sinh dưỡng | Chỉ tế bào sinh dưỡng |
| Chịu nhiệt | Tốt (lên đến 80°C+) | Kém (chết > 50°C) |
| Chịu axit dạ dày | Rất tốt (>90% sống sót) | Kém (Cần công nghệ bao phim) |
| Ứng dụng chính | Ruột non, xử lý nước, xử lý đáy | Ruột non, lên men thực phẩm |
Bạn cần hỗ trợ cụ thể nào tiếp theo?
Hãy để lại bình luận để chuyên gia hỗ trợ bạn ngay!
 YUCCA BEST POWDER - Bổ sung vào thức ăn giúp xử lý Amoniac, giảm FCR, xử lý mùi hôi cho ao tôm
1 × 299.000 ₫
YUCCA BEST POWDER - Bổ sung vào thức ăn giúp xử lý Amoniac, giảm FCR, xử lý mùi hôi cho ao tôm
1 × 299.000 ₫ ECO-PRO - Khoáng ngừa cong thân đục cơ, cứng vỏ nhanh, bổ sung khoáng chất trong ao nuôi
1 × 269.000 ₫
ECO-PRO - Khoáng ngừa cong thân đục cơ, cứng vỏ nhanh, bổ sung khoáng chất trong ao nuôi
1 × 269.000 ₫